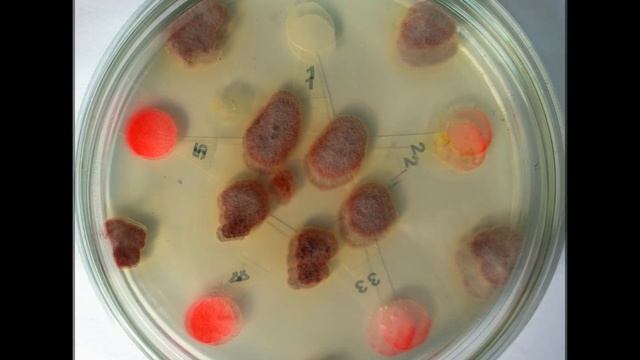
Microbiology experiment - Testing a fungicide with Fusarium oxysporum смотреть онлайн

Автор: Строительный Калейдоскоп Страница 6

Дымогенератор из трубы 120х120 своими руками

роспись стен . цветы

Измерение уровня воды и автоматический контроль

Деревообрабатывающий станок БЕЛМАШ УНИВЕРСАЛ 2000

Теплица капелька от завода Статус

Что полезного можно извлечь из струйного ПРИНТЕРА. РАЗБОР СТРУЙНОГО ПРИНТЕРА.

Покрытие дерева маслом OSMO / стол "Инопланетянин"

Фасадная сетка плотность 100 гр. Сетка для дачи, дома, строительных лесов. ДИРС Обзор

Мобильные дома для проживания. Технологии строительства мобильных домов. Чебоксарский завод СТЭП

Коллекция золотых крестов ювелирного завода Голден Глоб

Быстрое обрамление входной двери

ДПР-10В состав. Двухпозиционный объемный радиоволновой извещатель ДПР-10В.

Деревья - добыча древесины | Genshin Impact 1.5

Мои цветы. Обзор сортов. Приглашаю за цветами. Санкт-Петербург.

Разгрузка для фотографа из натуральной кожи
Microbiology experiment - Testing a fungicide with Fusarium oxysporum

Азарина на свадьбе танцует

Пенсильванская вишня, маньчжурский орех, тополя и сирень. Первоуральск озеленяют

Олимп 005С ДУ.

Ответы на Ваши вопросы. Питомник нимфей Waterlilia.ru отвечает на Ваши вопросы! Часть 11

Тайга! Один, на строительство! | Погода | Пурга, Метели! Пробил путики. Подготавливаю Избу к Сени!

Новогодняя игрушка подвеска на елку Бабочка из лент. Christmas toy tree butterfly quilling ribbons

Новая Bluetooth колонка Xiaomi Mi Speaker V2 - стильная штучка

Теплая грядка на садовом участке
За каждым успешным каналом стоит личность, идея и сотни часов кропотливого труда. Если вы здесь, значит, автор «Строительный Калейдоскоп» уже сумел зацепить ваше внимание своим уникальным стилем или подачей. А мы на RUVIDEO позаботились о том, чтобы вы могли изучить весь архив его работ в максимально комфортных условиях — без лишней суеты и преград.
Почему за работами канала «Строительный Калейдоскоп» так интересно наблюдать? Всё просто: это честный контент, который находит отклик в сердцах зрителей. На нашем ресурсе вы можете смотреть онлайн все видео любимого автора бесплатно и в хорошем качестве. Нам важно, чтобы вы видели каждую деталь и слышали каждый нюанс, поэтому мы используем только стабильные плееры из открытых источников Rutube.
Следите за новинками канала, пересматривайте старые шедевры и открывайте для себя новые грани творчества «Строительный Калейдоскоп». Мы постоянно обновляем ленту, чтобы у вас под рукой всегда были самые свежие выпуски. Никаких сложных регистраций — только вы и творчество, которое вдохновляет. Приятного вам путешествия по миру авторского контента на RUVIDEO!
Видео взято из открытых источников Rutube. Если вы правообладатель, обратитесь к первоисточнику.